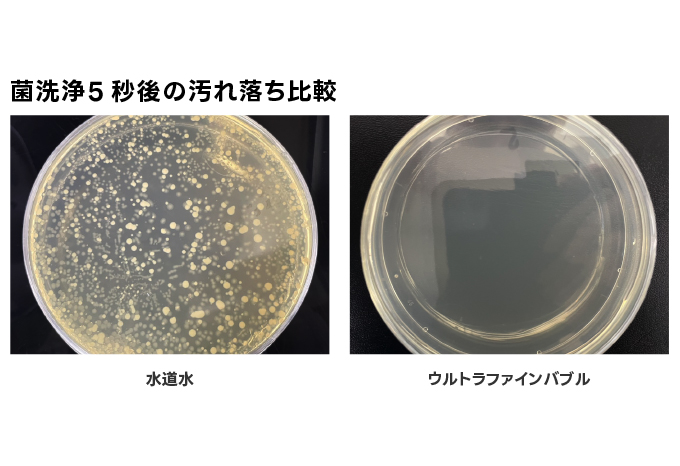
菌洗浄5秒後の汚れ落ち比較実験

導入事例・活用事例
-

ピンク汚れの原因菌が79%減少
2026.02.26実験
-

排水管汚れの残存率減少
2025.12.16実験
-

水垢を抑制し、水垢付着量36.9%低減
2025.12.16実験
-

洗車の仕上がりが綺麗に
2025.12.11実験
-
水まわりの汚れを軽減
2025.12.03実験
-

化粧品のクレンジング力アップ
2025.11.19実験
-

食器洗いの時間を短く、水の使用量を節水
2025.11.14実験
-

水の洗浄力を高め、短い時間で汚れを洗浄
2025.10.31実験
-

給水配管につなげるだけで飲食店の水洗金具からウルト...
2024.11.19節水

